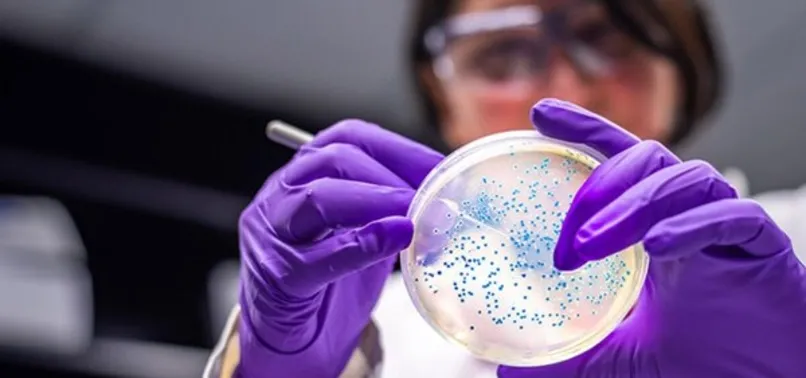
Çin'den koronavirüsün kökenine yönelik araştırmayı reddetti! DSÖ'nün hamlesine karşı son dakika açıklaması

Çin'den koronavirüsün kökenine yönelik araştırmayı reddetti! DSÖ'nün hamlesine karşı son dakika açıklaması
Çin'den Dünya Sağlık Örgütü'nün kökeninin araştırılmasına yönelik ikinci aşama planını kabul etmeyeceğini açıkladı. Koronavirüsün Çin'deki bir laboratuvarda üretildiğine yönelik iddiaların bir söylentiden ibaret olduğunu söyleyen Çin Ulusal Sağlık Komisyonu Bakan Yardımcısı Zıng Yişin bu durumun oldukça şaşırtıcı olduğunu ifade etti. Peki koronavirüs nerede üretildi? Koronavirüs üretildi mi?
Çin, Dünya Sağlık Örgütü'nün (DSÖ) yeni tip koronavirüsün (Kovid-19) kökenine dair ikinci aşama planını kabul etmeyeceğini bildirdi.
"OLDUKÇA ŞAŞIRDIM"
Çin Ulusal Sağlık Komisyonu Bakan Yardımcısı Zıng Yişin, yaptığı açıklamada, Kovid-19'un kökenine dair araştırmanın ikinci aşamasının, virüsün, bir Çin laboratuvarından sızmış olabilme ihtimalinin daha fazla araştırılmasını içermesine "oldukça şaşırdığını" ifade etti.

"KABUL ETMEMİZ OLANAKSIZ"
Bakan Yardımcısı Zıng, Kovid-19'un laboratuvardan çıktığı fikrinin "sağduyu ve bilime aykırı bir söylenti" olduğunu kaydederek, ikinci aşama planını reddetti. Basın toplantısında konuşan Zıng, "Böyle bir 'köken takip etme planını' kabul etmemiz olanaksız." ifadesini kullandı.

ARAŞTIRMANIN İLK AŞAMASI, ŞUBATTA SONA ERMİŞTİ
DSÖ, Kovid-19'un kökenine ilişkin soruşturmanın ikinci evresinde, Çin'i, daha fazla iş birliği yapmaya çağırmıştı.
DSÖ Genel Direktörü Tedros Adhanom Ghebreyesus, 16 Temmuz'da yaptığı açıklamada, Çin'e salgının ilk zamanlarına ilişkin şeffaflığını artırmaya ve virüsün kökenini çözmeye yardımcı olmak için laboratuvarlarına daha fazla erişime izin verme çağrısında bulunmuştu.
Salgının kökenine dair yapılan araştırmanın ilk aşaması, şubatta sona ermişti.






